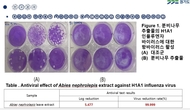

-

[오늘의 증시일정](12일)
- 2026-02-12 08:24
- 관리자 기자
-

[전국 주요 신문 사설](12일 조간)
- 2026-02-12 08:03
- 관리자 기자
-

[전국 주요 신문 톱뉴스](12일 조간)
- 2026-02-12 08:02
- 관리자 기자
-

"뇌 전두엽·두정엽 자극하면 이타적 행동 촉진할 수 있다"
- 2026-02-12 07:45
- 관리자 기자
-

담배 안 피우는데 폐암?…"만성 폐질환 있으면 폐암 위험 3배"
- 2026-02-12 07:43
- 관리자 기자
-

설 연휴 열 나는 우리 아이, 집에서 해열제? 응급실?
- 2026-02-12 07:42
- 관리자 기자
-

병원 옮겨도 진료기록은 이어져…정보교류 참여 의료기관 1만곳
- 2026-02-12 07:41
- 관리자 기자
-

[연합뉴스 이 시각 헤드라인] - 07:30
- 2026-02-12 07:40
- 관리자 기자
-

유한양행, 23년 연속 '존경받는 기업' 제약 부문 1위
- 2026-02-11 23:50
- 관리자 기자
-

녹십자 리소좀 축적 질환 치료제, 비임상서 효능
- 2026-02-11 22:49
- 관리자 기자
-

제이엘케이, 뇌졸중 AI 플랫폼 글로벌 협의 확대
- 2026-02-11 19:49
- 관리자 기자
-

동구바이오제약, 노바셀테크놀로지서 펩타이드 면역치료제 기술 도입
- 2026-02-11 19:49
- 관리자 기자
-

광동제약 '침향환' 누적매출 1천600억원 돌파
- 2026-02-11 19:48
- 관리자 기자
-

AI 병상 '씽크'가 살렸다…심정지 위기 조기 차단
- 2026-02-11 18:14
- 관리자 기자
-

시민·환자단체 "의대 증원 규모 부족…위기 외면한 정부 규탄"
- 2026-02-11 18:11
- 관리자 기자
-

설연휴에 2천780만명 이동, 작년 13%↓…10명 중 3명 '여행계획'
- 2026-02-11 13:37
- 관리자 기자
-

복지부, 지역 거점병원·동네의원 협력체계 구축 지자체 모집
- 2026-02-11 13:36
- 관리자 기자
-

폐기 대상 전자담배 기기도 우편망으로 회수한다
- 2026-02-11 13:35
- 관리자 기자
-

경기도산림환경硏, 분비나무·운금만병초 항바이러스 효능 규명
- 2026-02-11 13:34
- 관리자 기자
-

[오늘의 주요 일정](11일·수)
- 2026-02-11 08:30
- 관리자 기자
-

[오늘의증시일정](11일)
- 2026-02-11 08:29
- 관리자 기자
-

[전국 주요 신문 사설](11일 조간)
- 2026-02-11 08:09
- 관리자 기자
-

[전국 주요 신문 톱뉴스](11일 조간)
- 2026-02-11 08:09
- 관리자 기자
-

[연합뉴스 이 시각 헤드라인] - 07:30
- 2026-02-11 07:42
- 관리자 기자
- 1 '75세 넘은 노인, 정상 혈압수치 밑돌면 사망 위험↑"
- 2 [명의에게 묻다] 폐에 2㎝ 넘는 덩어리 '간유리 결절'…절반은 폐암 위험
- 3 ·코로나19 무력화하는 항체 찾아…백신 개발에 기여 기대
- 4 보험업계 "내년 실손보험 인상률 평균 8.9%"
- 5 국민 65% "일상생활 재개하면 코로나19 감염위험 커질 것"
- 6 "이식 신장 수명 다하면 재이식이 최선"
- 7 중국 외 국가에서는 왜 신종코로나 사망자 드물까?
- 8 손목, 팔꿈치터널증후군 진료인원 16만명...스트레칭이 도움
- 9 대장암 AI(인공지능)로 정확히 판별…국내 개발
- 10 "췌장 베타 세포 '칼슘 채널' 당뇨병 유발 메커니즘 찾아내"
- 의료.병원.한방의협 "통합돌봄, 방문진료 참여기반 불충분…의료인 보상 과제"
- 학회.학술.건강"감염병 대응 역량 강화" 질병청·국립중앙의료원 국제심포지엄
- 메디칼산업감염 막는 4중 방어막…세스코 다중시설 '바이러스케어' 공개
- 사람들연골 및 골관절염 학회장에 김석중 의정부성모병원 교수
- 라이프AI시대 명상으로 마음 돌봄…조계종 선명상대회 내달 3일 개막
- 평생교육AI가 '복지 위기가구' 초기 상담…11월부터 전국 확대
- 문화.관광쌀값, 최대 26% 치솟아…"송미령 장관 쌀정책 오락가락"
- 반려동물"함부로 옮기지 마세요"…'길고양이 돌봄 가이드라인' 개정
- 오늘의일정[오늘의 주요 일정](26일·목)
- 의료.병원.한방·코로나19 무력화하는 항체 찾아…백신 개발에 기여 기대
- 학회.학술.건강'75세 넘은 노인, 정상 혈압수치 밑돌면 사망 위험↑"
- 메디칼산업"저용량 아스피린, B형·C형간염→간암 진행 억제"
- 사람들[부고] 김재중(서울아산병원 교육부원장)씨 모친상
- 라이프뱀 없는 울릉도에 뱀 출몰…어디서 왔나
- 평생교육천주교 수원교구 오로지 복지법인, 직원 의료지원 발벗고 나서
- 문화.관광전국 출렁다리 150개…'출렁출렁' 어지러운 대한민국
- 반려동물맹견 책임보험 12일부터 의무화…위반시 최대 300만원 과태료
- 오늘의일정[주요 신문 사설](11일 조간)